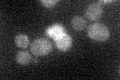
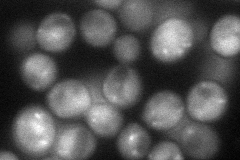
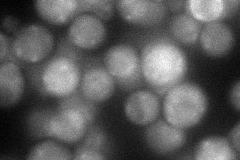
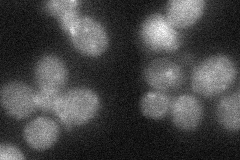

View description
Small subunit of the clathrin-associated adaptor complex AP-3, which is involved in vacuolar protein sorting; related to the sigma subunit of the mammalian clathrin AP-3 complex; suppressor of loss of casein kinase 1 function
Localization:
Intensity:
Fold change:
Significance:
-
C’ GFP library in SD
punctate16.13 -
N' NOP1pr-GFP in SD
cytosol,punctate77.53 -
N' TEF2pr-mCherry in SD
cytosol,punctate59.215 -
N' NATIVEpr-GFP in SD
punctate33.5257 -
N' TEF2pr-VC and Cyto-VN in SD

below threshold24.9076 -
C’ GFP library in SD+DTT

punctate17.531.08No -
C’ GFP library in SD+H2O2

punctate14.530.9No -
C’ GFP library in Starvation Media

punctate16.81.04No -
C’ GFP library on the background of Pup2-DaMP

punctate -
C’ GFP library on the background of CCT mutant

punctate15.38040.953492No
